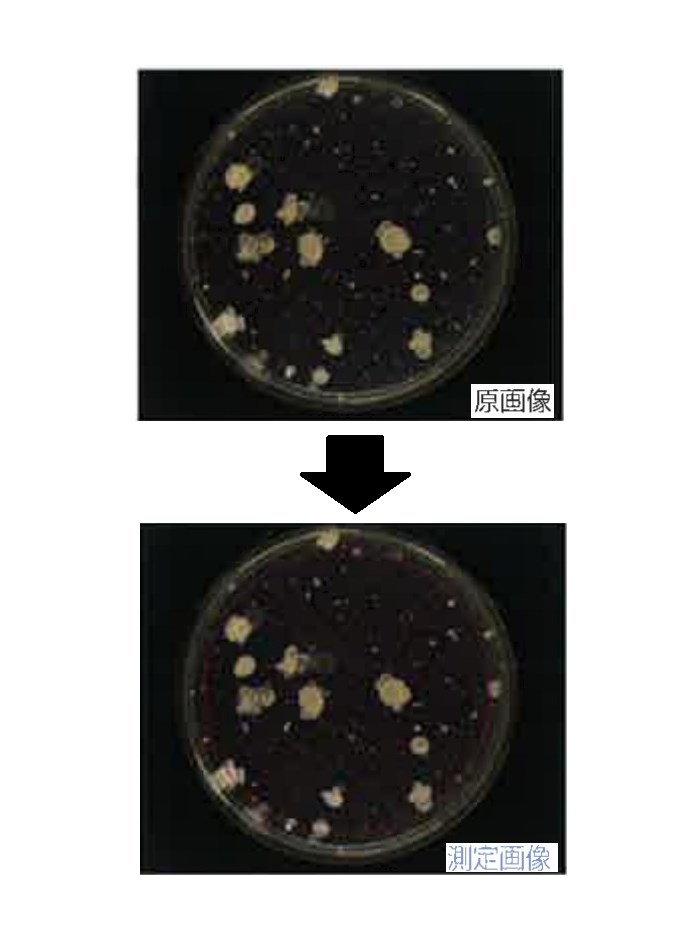
コロニーカウンタ 企業6社の製品とランキング Ipros

√ダウンロード コロニー 形状 種類 259518-コロニー 形状 種類
™ mccda クリアーht 寒天培地 カンピロバクターの選択分離培地 培地が透明でコロニーがクリアーに見える さまざまな形態のコロニーも見落とさない 高い選択性で夾雑菌に邪魔されない 18 ※上記価格は平成30年3月現在のものです。上記価格は予告なく変更する場合がありますのでコロニー形状種類, 大腸菌 大きさは通常短軸0407µm、長軸40µmだが、長軸が短くなり球形に近いものもいる 。 細菌の代表として モデル生物 の一つとなっており、各種の研究で材料とされるほか、 遺伝子 を組み込んで 化学物質 の生産にも利用される(下図)。発明の詳細な説明 技術分野 0001 本発明は、人間および哺乳動物のストレス緩和を目的とした組成物、これらを含む飲食品、栄養補助食品、健康食品、機能性食品または医薬品に関する。

一般生菌と微生物検査の補足 完結 食品の品質デザイナーをブランドに
コロニー 形状 種類
コロニー 形状 種類-727円 USA在庫あり コロニー Colony Machine キック スターター スプリング スタッド 52年70年 XL/K/KH シルバー HD店 車用品・バイク用品 バイク用品 その他 h&iグローバルリサーチ(株) ***** マーケットレポートjp「peg化タンパク質治療薬の世界市場:製品の種類別(コロニー刺激因子、インターフェロン、エリスロポエチン(epo)、遺伝子組換え型血液凝固第v 続きを読む →




作業環境の微生物検査 落下菌の測定と発生原因 食品の品質デザイナーをブランドに
メートル並目ネジ JIS B05 M M4 60度 管用平行ネジの基準寸法 ※単位mm ネジの呼びサイズ ネジの山数 (254mmにつき)③ 2次選択(形状絞込み) 次にコロニーの輪郭・形状等を指定して絞込みを行います。 5 種類のパラメーターの組み合わせで様々な絞込みが行えます。 たピクセル数以下の場合を除外します。 楕円、コロニーの面積比: 円周と面積の比(真円の場全文検索できるプレミアムサービスを開始しました 日本語表現インフォ > 感覚表現 > 形状の表現・描写 形状 の表現の一覧 らせん状 突き出た 溝(みぞ) 厚み(厚い・薄い) 四角・角ばっている 穴
( 黒 ) 色のコロニー検体 セレウス菌フードスタンプより ( 赤 ) 色のコロニー検体 培地の色・コロニーの形状・他の細菌の混入などが分かるよう に色鉛筆を使ってスケッチすること. サルモネラ 記入例 重要部分のみ 拡大図 重要部分のみ 拡大図Colony Survival is a unique firstperson strategy game developed by a twoman team Build your own colony in a voxel world Command guards, farmers, miners and other colonists Defend your colony against the horde of monsters that attacks every night!2576円 ホンダ スーパーカブ シート本体 ヒンジ付き ブラック ホンダ カブ用 cub c50 c70 c90 c110 カスタムパーツ 送料無料 スーパーカブ用 シート ヒンジ付き スーパーカブ50 70 リトルカブ 純正タイプ 外装 パーツ 社外品 c50 c70 c90 c110 ja07 dx std 車用品・バイク用品 バイク用品 パーツ
鉄筋の種類 鉄筋の径に 鉄筋の折曲げ d 余 長 4d 以 余長4d以上 上 幅止め筋 よる区分 内法直径(D) 図21 幅止め筋の形状 余長8d 以上 余長8d 以上 上下スラブ付 L1h※ 余 長 6 d 以 上 ※L1h(フック付重ね継手)は、表311による。 図236 副あばら筋・副帯筋の形状コロニーカウンターライト台 0×2×50mm R2D2 ライト台は左右どちらにも取り付け可能な拡大鏡付きで、カウント作業以外にもお使いいただけます。 本体からの発熱の影響を抑えるための通風口を設けています。 1 種類の製品があります 標準価格: 32,000 円 WEB価格: 商品詳細へ アズワンのAXELショップ発明の詳細な説明 技術分野 0001 本発明は、人間および哺乳動物の肥満の予防、治療、改善を目的とした組成物、これらを含む飲食品、栄養補助食品、健康食品、または機能性食品に関する。




日水製薬 コスモ会 コスモ会質問箱 Q A




日水製薬 コスモ会 コスモ会質問箱 Q A
特許第669号(P669) IP Force 特許公報掲載プロジェクト β版Colony stimulating factor 1 receptor (CSF1R), also known as macrophage colonystimulating factor receptor (MCSFR), and CD115 (Cluster of Differentiation 115), is a cellsurface protein encoded, in humans, by the CSF1R gene (known also as cFMS) It is a receptor for a cytokine called colony stimulating factor 1ピンピッチは 10mm,08mm,065mm,05mm,04mm,03mm など様々な種類がありますが、ピンピッチが狭くなるにつれてリードピンが曲がりやすくなるので注意してください。 なお、ガルウィング形 (L字形)のリードがパッケージの 2側面 から出ているものは、 SOP (Small Outline Package) と呼ばれています。 QFPでも様々な種類があります (BQFP,GQFPなど)。 各種類の詳細 と QFPに関す



Yg Kobe Wu Ac Jp




微生物カテゴリー 細菌 酵母 カビ の識別方法 株式会社テクノスルガ ラボ
JPB2 JPA JPA JPB2 JP B2 JP B2 JP B2 JP A JP A JP A JP A JP A JP A JP B2 JP B2 JP B2 Authority JP Japan Prior art keywords sheet mount culture microorganism culture thickness Prior art date Legal通常のコロニー クリーム色・丸型・粘性が高い 異なるコロニー やや透明がかったクリーム色・不定形・粘性は低い それぞれの菌をSCDLP培地にてストリークしたところ, それぞれにおいて上記形状の均一なコロニーが出現しました。コンタミではないかということで同定試験を行いましたが,同一菌種 (Klebsiella oxytoca) であると言う結果に至りました。 同定方法Trichophyton quinckeanum may be distinguished from T mentagrophytes by (a) its characteristic culture appearance on Littman oxgall agar (ie raised, domelike, bluishgrey suedelike colony with a narrow flat, greyishwhite, suedelike border and no diffusible or reverse pigment) and on Sabouraud's 5% salt agar (typically heaped and folded white suedelike colony, but with no



Katosei Jsbba Or Jp




大腸菌 Wikipedia
日常使いとして 旅行に最適 COLONY 財布 財布/小物2139(コロニートゥーワンスリーナイン)のファッション ビットつき三つ折りウォレット(財布)|COLONY 価格からギフトを探す ¥2,000以下 ¥2,001~¥3,000 ¥3,001~¥4,000 ¥4,001~¥5,000 ¥5,001以上日本と外国ではコンセントの形が違います。 国によってコンセントの形状も様々。 日本はAタイプ(日本・アメリカタイプ)なので、それ以外のコンセント形状の国で電気製品を使用する場合、その国のコンセントにあったプラグをつけなくては使用できません。 主たる世界のコンセント形状 ※同一国内でも地域・ホテルにより形状が違います。 また、上記表に第19章 グラム陽性菌 細胞壁の厚い外膜のない菌である。形により、球菌 (coccus)とかん菌 (rod) に分ける。



Lab2 Toho U Ac Jp




05 0559号 微生物または細胞の計測方法及び装置 Astamuse
さらに、観察するコロニーの大きさ(だいた い差し渡し 5 cm 程度)に比して寒天平板が薄い(3 mm 程度)ので、我々 のバクテリアコロニーの成長は準2次元的なパターン形成とみなしてよいで



細菌コロニー同定装置およびその方法




日水製薬 コスモ会 コスモ会質問箱 Q A




Uzivatel 京都酵母ブランド化計画 日本酒の味は酵母がつくる 公式 Na Twitteru 研究所の年末の大掃除の際に出てきた古いファイル 上司に聞くと 色々な組成の培地上で 酵母に3 4 Cmのジャイアントコロニーを 形成させて その 形状から酵母の種類を 判別する




クレンゼ キットの使い方 クレンゼ キット クラボウ



Setsunan Ac Jp




Pharm Tech Japan Vol 32 寒天培地培養法の迅速化を可能にしたタイムラプス影像解析法 日本bd




カビ Wikipedia



タイムラプス影像解析法 微生物迅速検出法



Report1




腸管系細菌 細菌の検査 各論 神奈川県衛生研究所




Pharm Tech Japan Vol 32 寒天培地培養法の迅速化を可能にしたタイムラプス影像解析法 日本bd




酵母形態観察および生理 生化学的性状試験 株式会社テクノスルガ ラボ



Jst Go Jp




ブドウ球菌 Wikipedia




カビ対策マニュアル 基礎編 文部科学省




クレンゼ キットの使い方 クレンゼ キット クラボウ




Uzivatel 京都酵母ブランド化計画 日本酒の味は酵母がつくる 公式 Na Twitteru 研究所の年末の大掃除の際に出てきた古いファイル 上司に聞くと 色々な組成の培地上で 酵母に3 4 Cmのジャイアントコロニーを 形成させて その 形状から酵母の種類を 判別する




ガンダムのスペースコロニーや小惑星の位置関係




日水製薬 コスモ会 コスモ会質問箱 Q A



Kaken Nii Ac Jp




コロニーカウンター Protocol3 アプリケーションノート 株式会社セントラル科学貿易

コロニーカウンタ 企業6社の製品とランキング Ipros



Multimedia 3m Com



コロニーカウントグラフ 2種類の菌を同時検出したときの計数グラフ例です




Uzivatel 京都酵母ブランド化計画 日本酒の味は酵母がつくる 公式 Na Twitteru 研究所の年末の大掃除の際に出てきた古いファイル 上司に聞くと 色々な組成の培地上で 酵母に3 4 Cmのジャイアントコロニーを 形成させて その 形状から酵母の種類を 判別する




アピ20




05 0559号 微生物または細胞の計測方法及び装置 Astamuse



大学で微生物の実験をしています 真菌のコロニーの数え方なのですが 培養期間まで Yahoo 知恵袋



検査部 検査室紹介




微生物検査におけるメンブレンフィルター法 Mf法 Cytiva




コロニー標本 株式会社アテクト




微生物検査におけるメンブレンフィルター法 Mf法 Cytiva




微生物学研究室の教育のための土壌試料から寒天プレート上に生育する細菌とカビの特性と異なる形状のコロニーの背景 アイデンティティーのストックフォトや画像を多数ご用意 Istock




細胞コロニーにみられる 動的スケーリング則 の不思議 実験と数理モデルから明らかになったこと Academist Journal




11 号 細菌コロニー釣菌装置及びその方法 Astamuse




カビ形態観察 株式会社テクノスルガ ラボ




カビ対策マニュアル 基礎編 文部科学省



Ina Janis Or Jp



Www Np Acs I Kyoto U Ac Jp



Hro Or Jp




12 号 細菌コロニーの釣菌方法及び釣菌装置 Astamuse



Gair Media Gunma U Ac Jp




腸管系細菌 細菌の検査 各論 神奈川県衛生研究所



Report1




酵母premium 株式会社テクノスルガ ラボ



学術局 全国労災病院臨床検査技師会




作業環境の微生物検査 落下菌の測定と発生原因 食品の品質デザイナーをブランドに



Kaken Nii Ac Jp




Aシンプルパターン 上5種類 Bカラフルパターン 下5種類 メール便可 Abどちらかお選びください 5コセット 日本製 よく消える消しゴム Re040 チョコ Zi Keshi チョコ磁ケシ Web限定 鉄粉入消しゴム




Sitesirius P 191 図 1 コロニーの観察の一例 測定



真菌



枯草菌




一般生菌と微生物検査の補足 完結 食品の品質デザイナーをブランドに




正体はコレ 細胞培養でのコンタミの原因と対策 Learning At The Bench



Bunshi4 Bio Nagoya U Ac Jp




スペースコロニーの配置 ガンダム入門塾



イネ種子からのもみ枯細菌病菌及び褐条病菌の効率的な生菌回収法




平成24年基礎微生物学 第1回 平成24年4月11日 担当 前田伸子 Ppt Download




背景の特性と異なる形のコロニーの細菌や微生物検査室における教育の土壌サンプルから寒天版で育っているカビ アイデンティティーのストックフォトや画像を多数ご用意 Istock




住宅環境中のカビ 研究員オダの環境レポート



検査室タイムズ Tekari 臨床検査技術部




微生物検査におけるメンブレンフィルター法 Mf法 Cytiva



学術局 全国労災病院臨床検査技師会



Products Kanto Co Jp




多能性幹細胞 Naive型とprimed型多能性




一般生菌数用 標準寒天培地 株式会社アテクト



微生物




微生物学研究室での教育のための土壌サンプルから寒天プレート上に成長する細菌とカビの特性と異なる形状のコロニーの背景 アイデンティティーのストックフォトや画像を多数ご用意 Istock




05 0559号 微生物または細胞の計測方法及び装置 Astamuse




カビ対策マニュアル 基礎編 文部科学省




Culturing And Enumerating Bacteria From Soil Samples Protocol Translated To Japanese




スペースコロニー Wikipedia



1




細菌コロニーと真菌コロニーの違い 類似用語の違いを比較する 理科 21



Repository Kulib Kyoto U Ac Jp




生物基礎 肺炎双球菌の形質転換 グリフィスの実験とアベリーの実験 Biology Tips 高校生物のワンポイント解説




05 0559号 微生物または細胞の計測方法及び装置 Astamuse



藤元メディカルシステム 先端医療講座 Klebsiella Pneumoniae 肺炎桿菌




菌のお顔拝見 Log Cfu たいすうきんすう



Kobe Tokiwa Ac Jp



Kaken Nii Ac Jp



食品ネット分析室 細菌一般



Katosei Jsbba Or Jp




細菌の調べ方 Nhk For School



Report1




大腸菌群用 デソキシコレート寒天 株式会社アテクト




Pharm Tech Japan Vol 32 寒天培地培養法の迅速化を可能にしたタイムラプス影像解析法 日本bd




正体はコレ 細胞培養でのコンタミの原因と対策 Learning At The Bench




Pharm Tech Japan Vol 32 寒天培地培養法の迅速化を可能にしたタイムラプス影像解析法 日本bd




カビ形態観察 株式会社テクノスルガ ラボ



Kaken Nii Ac Jp




Uzivatel 京都酵母ブランド化計画 日本酒の味は酵母がつくる 公式 Na Twitteru 研究所の年末の大掃除の際に出てきた古いファイル 上司に聞くと 色々な組成の培地上で 酵母に3 4 Cmのジャイアントコロニーを 形成させて その 形状から酵母の種類を 判別する




微生物分離 株式会社テクノスルガ ラボ




バイオ通信 No 1584 手指の細菌を見てみよう 応用生物科学科blog



Katosei Jsbba Or Jp



Kaken Nii Ac Jp
コメント
コメントを投稿